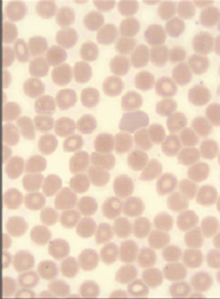
Hematology Case Study - Thrombocytopenia Image #2

Hematology Case Study - Thrombocytopenia
Download PDF
This 71 year old male (see PDF) presented with markedly decreased platelet count of 8 X10^3/µL. Instead of a normal peak distribution, the platelet histogram depicts very few platelet cell events reflecting a low impedance platelet count. The fluorescent platelet count (PLT-F) was run on this sample according to lab protocol and is designated by an “&F” next to the result.
The PLT-F channel provides a more accurate platelet count than the impedance method, especially in cases of extreme thrombocytopenia. The fluorescent stain, Fluorocell™ PLT, binds specifically to platelet organelles and the counting time is extended for increased precision. The PLT-F channel also measures an Immature Platelet Fraction (IPF%).
Asterisks indicate that a result may be inaccurate. The IPF% may present with an asterisk in cases of extreme thrombocytopenia. If a “Retic Abnormal Scattergram” flag is present but there is no asterisk beside the associated reticulocyte values, the lab may report the reticulocyte parameters according to their procedures.
NRBCs are detected by the XN analyzer but not on the manual differential; this is due to the XN’s ability to count more cells with higher precision than the 100-cell manual differential.

The clinical applications or uses presented in these materials, including case studies, are provided for illustration purposes only. Prior to using any Sysmex device, please review the manufacturer’s instructions use. It is the healthcare provider’s responsibility to determine applicability in routine clinical practice.
Sigue leyendo Download PDF
